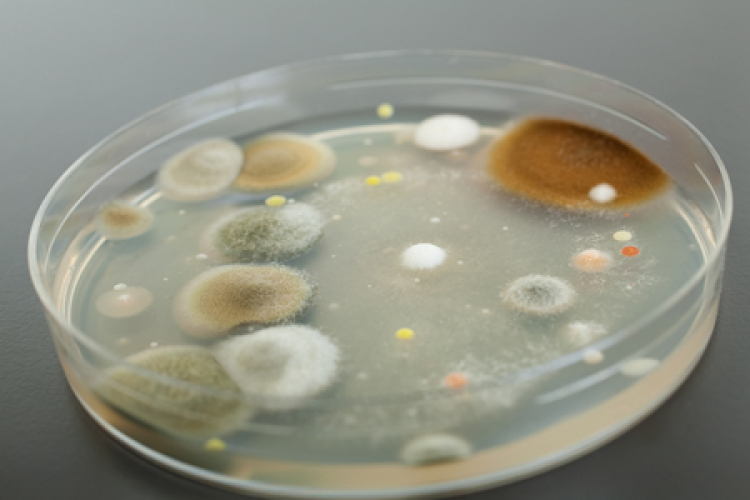
Madárinfluenza - Tiszti főorvos: Magyarországot nem fenyegeti veszély

Hírek
2013. Április 08. 14:44, hétfő | Belföld
Madárinfluenza - Tiszti főorvos: Magyarországot nem fenyegeti veszély
Magyarországot és az Európai Uniót nem fenyegeti a Kínában megjelent madárinfluenza veszélye - közölte az országos tiszti főorvos hétfői, budapesti sajtótájékoztatóján.
